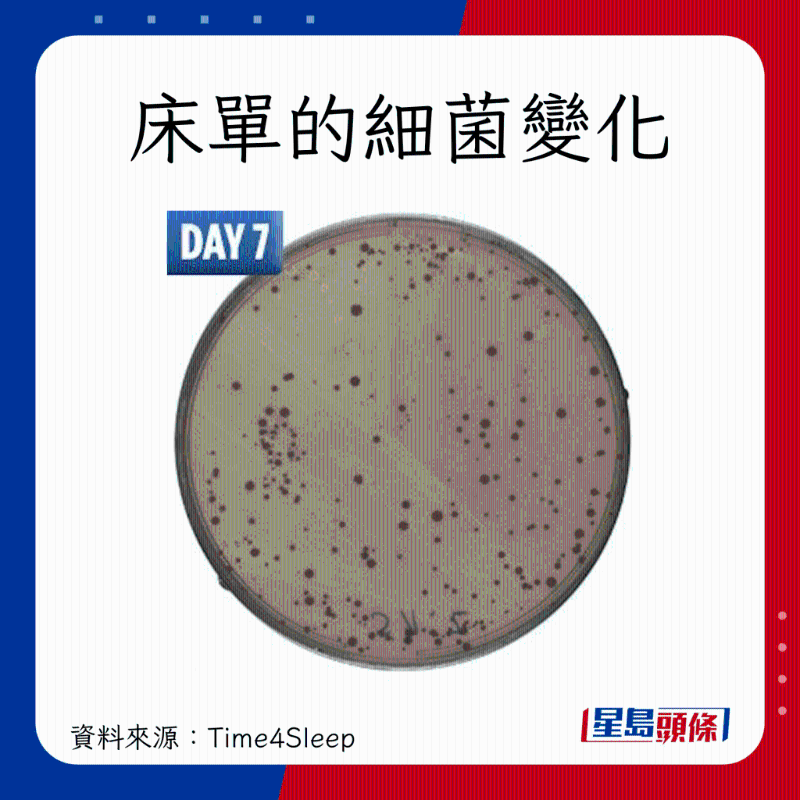
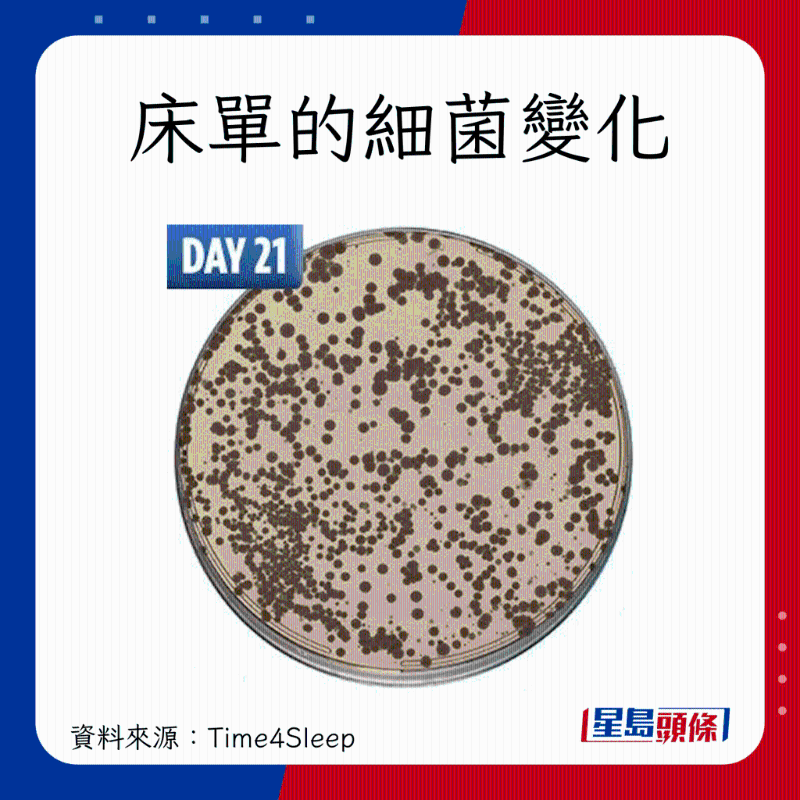

不换床单很易滋生细菌、尘螨,引发湿疹、脑膜炎? 不换床单短短一星期,床上尘螨可多达100万只,并容易引发11大健康问题。 英国有床褥公司进行研究,记录床单4星期的恐怖变化。 为免敏感患病,消委会教5大方法,可有效清除及预防尘螨。 下雨天环境潮湿,更要小心预防!
7日不换床单 100万只尘螨爬身
香港浸会大学裘槎环科所曾进行一项研究,发现香港家庭每1克灰尘含有4.2至46.7只尘螨,一张床褥潜藏的尘螨则多达10至100万只,尘螨致敏原浓度中位数达3.35微克。
尘螨靠吃人体皮屑生存! 消委会指,尘螨属蛛形纲节肢动物,是蜘蛛和蝎子的亲戚,有8只附吸盘的脚。 它体型非常小,约0.3毫米,故无法以肉眼看
不换床单细菌增激 4星期恐怖变化全面看
早前英国床褥公司Time4Sleep就更换床单的习惯进行调查,发现有40%受访者表示每2个星期才会更换床单; 有24%受访者更表示3至4个星期才会更换床单。 因此,床褥公司与西班牙塞维亚大学(Universidad de Sevilla)合作进行实验,用显微镜检验床单的含菌量,再观察床单在4星期内的细菌变化。
研究人员要求测试者连续28晚在同一张床上睡觉,期间不可以清洗或更换床单、枕套或被套。 团队每周会收集在枕头、床单的中央和底部的样本进行细菌测试,并记录下来。
结果发现,28天后培养皿已经布满细菌,包括梭杆菌目(Fusobacteria)、奈瑟菌目 (Neisseriales)等,另亦有尘螨。
不换床单引发11大健康问题 恐致湿疹脑膜炎
Time4Sleep的研究指出,梭杆菌目、奈瑟菌目等细菌,可能引致以下健康问题或疾病:
阑尾炎
蜂窝织炎
肺炎
雷米尔氏症
牙周病
淋病
脑膜炎
过敏和过敏反应
湿疹
暗疮
哮喘
细菌比黑猩猩巢穴多 专家揭床单最佳更换时间
研究结果证实了一种说法。 美国北卡罗来纳州立大学有研究指,人类床铺比黑猩猩巢穴含有更多细菌。 调查人员发现,这些细菌是源自人体皮肤、口腔和排泄物。
人体每天与床单、枕头接触的时间约为8小时,期间会沾染不少细菌。 研究人员提醒,每2星期就要更换一次床上用品,以保持身体健康、环境干净。
不洗床单满布尘螨 家居8对象高危
不经常清洁床单、枕头等物品,有机会令尘螨大量繁殖。 消委会指,尘螨最常寄居家中8大对象:床单、枕头、枕头布、枕头袋、床垫、被褥、地毡、毛公仔。
清除及预防尘螨5大方法
1. 清除尘螨方法
消委会教2大方法清除消灭尘螨,包括用热水洗及用阳光晒床品、用湿布抹家具,正确做法及注意事项如下:
方法1: 热水洗 + 阳光晒床品
每隔一至两星期以约60°C热水清洗床单、枕套等床品。天气晴朗时,将枕头、被铺或床单放置于室外晾晒3小时左右,亦有助减少尘螨!
方法2:用湿布抹家具
定期以湿布或吸尘机保持家居清洁,尽量避免使用干布、尘拂或扫帚打扫。
2.预防尘螨方法
用防螨床品就一定有效? 消委会教3大方法预防尘螨,做法如下:
方法1:使用防螨床品
方法2:减少尘螨寄居地
方法3:控制房间湿度
更多健康小常识,尽在星岛环球网:
睡觉突然抽搐一下=癫痫发作?医生揭有下坠感原因,出现4情况要求医
以上内容归星岛新闻集团所有,未经许可不得擅自转载引用。
《星岛申诉王》一百集啦!6月16日至30日期间,为了回馈广大观众的支持,特开展投票留言活动。参与活动即有机会赢取总价值超过10万的丰富礼品!
参与点击:你在香港受委屈?就找星岛申诉王!